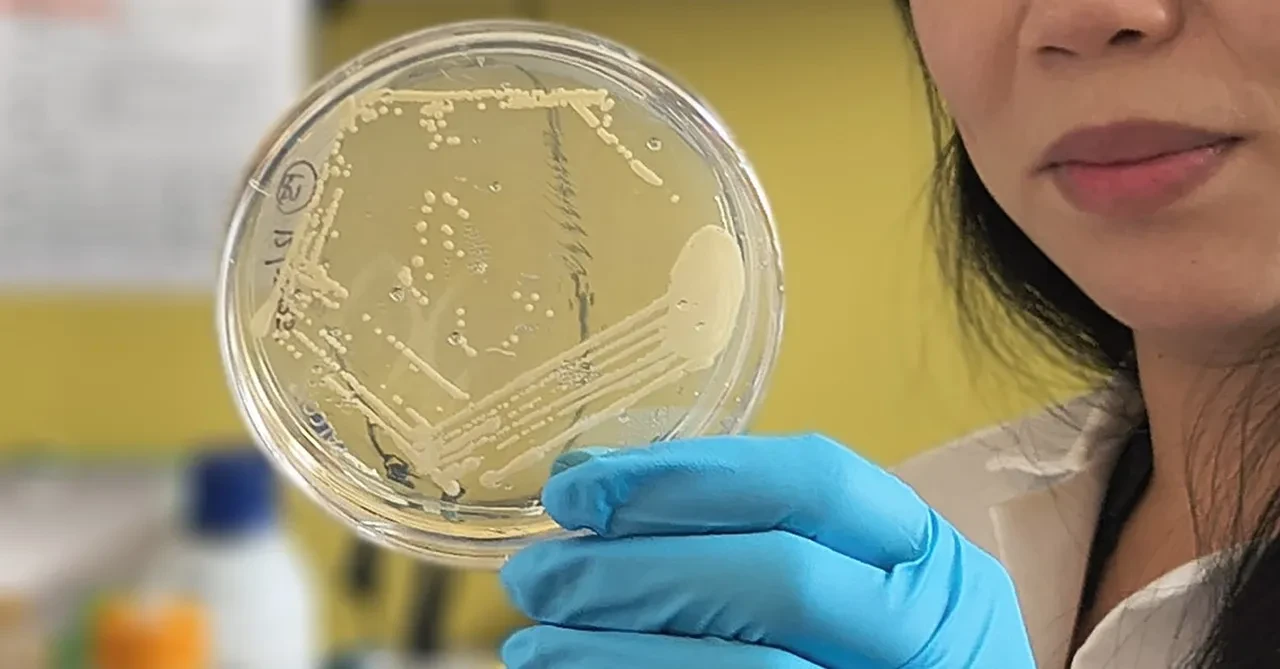
Vücudu kendi kendine alkol üretmeye başladı, kimseyi inandıramadı: Sağlığına dışkı nakliyle kavuştu
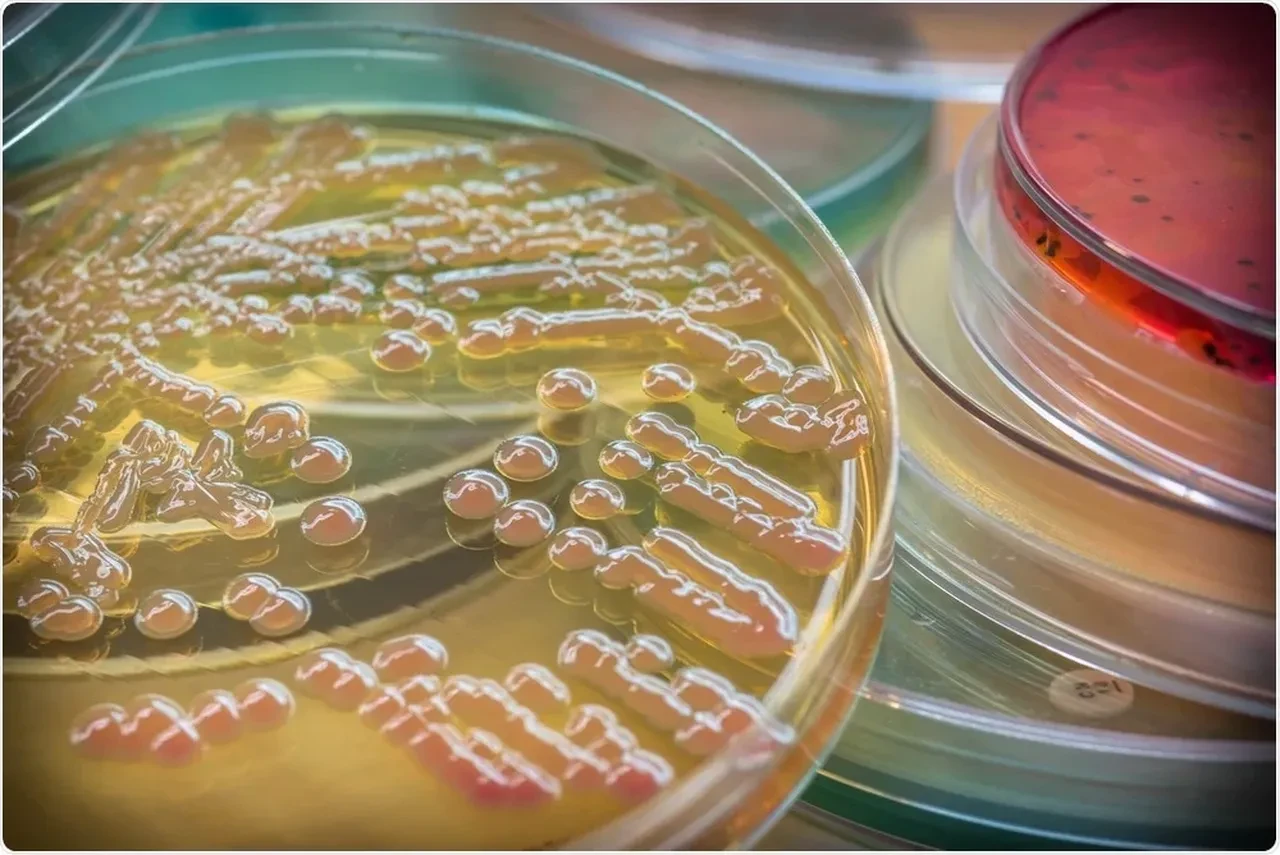
Vücudu kendi kendine alkol üretmeye başladı, kimseyi inandıramadı: Sağlığına dışkı nakliyle kavuştu

Kategoriler
UYGULAMALAR
İstanbul

ABD'de yaşayan emekli Deniz Piyadesi Subayı nadir görülen bir hastalığa yakalandı. 'Auto brewery sendromu' olarak bilinen vücudun kendi kendine alkol ürettiği, sürekli sarhoş gibi hissettiren hastalık dışkı nakliyle tedavi edildi.
Emekli subay prostat tedavisi gördüğü sırada farklı kürler kullandı ve alışık olmadığı belirtilerle karşılaştı. Ardından da hiç alkol tüketmemesine rağmen sarhoşluk hissi, sersemlik ve aşırı uyku hali gibi semptomlar belirdi.

New Scientist’in haberine göre, 60 yaşındaki subay, birkaç kez acil servise başvurdu fakat kimse alkol içmediğine inanmadı. Araştırmalar sonucunda bağırsaklardaki mikroorganizmaların yüksek miktarda alkol ürettiği son derece nadir bir hastalık olan “auto brewery sendromu” teşhisi konuldu.
Aşırı sarhoşluk hali, günlük yaşamını ciddi şekilde etkiledi. Yasal sınırların üzerinde alkollü araç kullanmamak için aracına bir alkolmetre kilidi taktırdı.

Bir hasta destek grubuyla iletişime geçen emekli subay, dışkı naklinin bu sendrom için umut verici bir tedavi yöntemi olarak değerlendirildiğini öğrendi. Bunun üzerine Massachusetts General Hospital’da dışkı nakli uygulayan enfeksiyon hastalıkları uzmanı Dr. Elizabeth Hohmann’a başvurdu.
Hohmann, hastanın kendisini sürekli aradığını ancak konuşmalarının sarhoş birini andırması nedeniyle başlangıçta bu çağrıları ciddiye almadığını belirterek, “Sürekli sesli mesaj bırakıyordu ve sarhoş gibi konuşuyordu, ben de onları görmezden gelmeye çalışıyordum,” dedi. Ancak daha sonra hastanın eşi durumu ayrıntılı şekilde anlattı.
Hohmann, vakayı California Üniversitesi San Diego’dan gastroenterolog ve auto brewery sendromu uzmanı Prof. Dr. Bernd Schnabl ile değerlendirdikten sonra dışkı nakli yapılmasına karar verdi.
Nakil öncesinde sendroma sahip 22 kişi ve 21 ev içi partnerin dışkı örnekleri incelendi. Schnabl, çalışmayla ilgili esprili bir dille, “Laboratuvarımız biraz kokuluydu,” ifadelerini kullandı.
Araştırma sonucunda, sendromu olan kişilerin dışkılarının laboratuvar ortamında yüksek miktarda alkol ürettiği belirlendi. Bunun, şekerleri fermente ederek doğal olarak alkol üreten bazı bağırsak bakterilerinin olağanüstü yüksek seviyelerde bulunmasından kaynaklandığı ortaya çıktı.
Dr. Hohmann, emekli subayın tedavisi için sağlıklı ve dengeli bir bağırsak mikrobiyotasına sahip erkek bir donörden elde edilen dışkıdan hazırlanan kapsülleri ağız yoluyla, birden fazla doz halinde uyguladı.
Zamanla, alkol üreten zararlı bakteriler yerini donörün daha sağlıklı bakteri topluluğuna bıraktı. Böylece emekli subayın auto brewery sendromu tamamen düzeldi ve hasta normal yaşamına geri döndü.